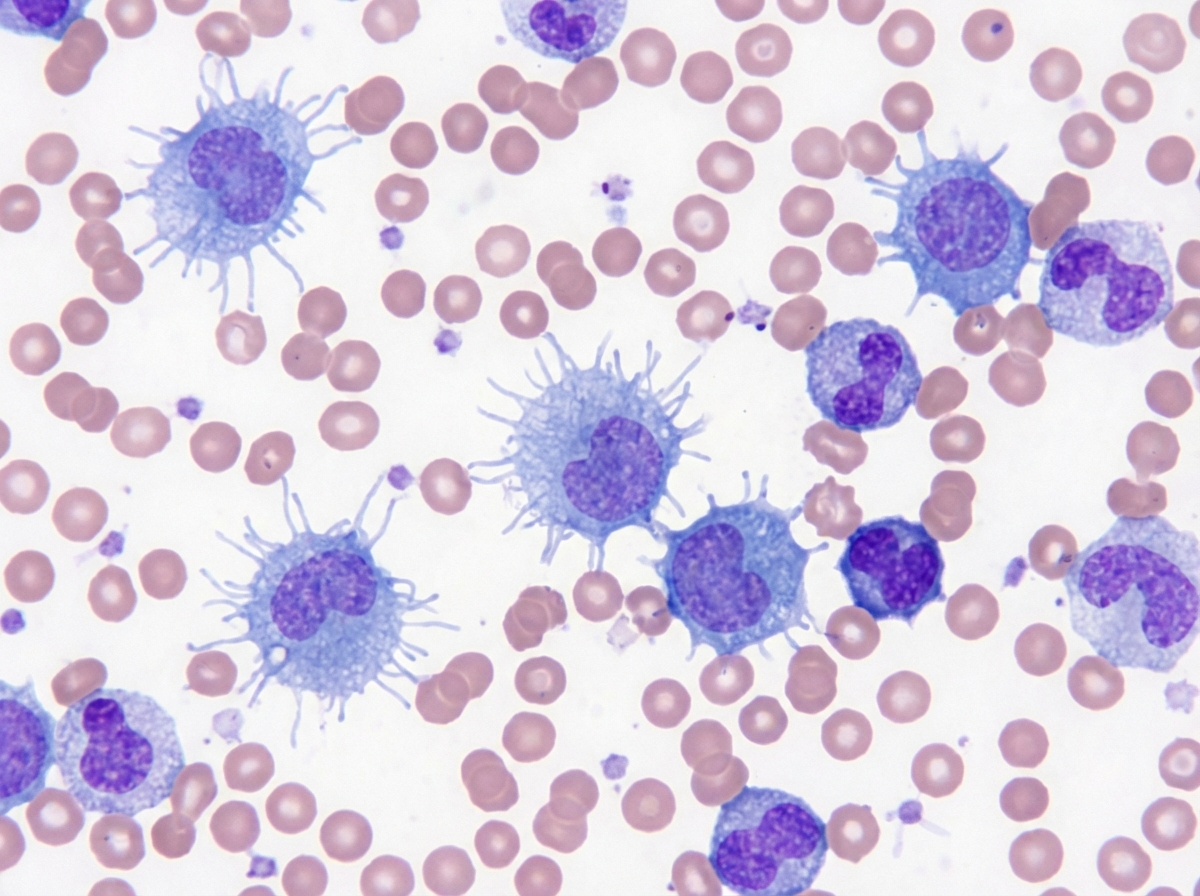
Image for question 1137

Target cells are seen in which of the following conditions?
Bence Jones proteinuria is found on a urinalysis specimen from a 63-year-old woman who is developing chronic renal failure with high serum urea nitrogen and creatinine. A radiograph of the vertebral column demonstrates multiple 1 to 2 cm rounded areas of decreased bone density. The pathological examination from a renal biopsy is likely to show which of the following complications?
In sickle cell anaemia, the defect is in which globin chain?
A patient presents with a lytic bone lesion. Histology reveals monoclonal plasma cells. Bone marrow biopsy shows less than 10 percent plasma cells, and a small M spike is reported on electrophoresis. Skeletal survey is otherwise unremarkable. What is the most likely diagnosis?
Platelets can be stored at what temperature and for how long?
At what concentration of methemoglobin does cyanosis appear?
A 50-year-old male presented with left upper quadrant pain. On examination, the spleen was palpable 10 cm below the left costal margin. A peripheral smear is shown. Which of the following immunohistochemical markers is used for the diagnosis of the condition?
Paroxysmal nocturnal hemoglobinuria (PNH) is a disease that results from defects in which of the following?
A 10-year-old male child presents with pallor and a history of blood transfusion 2 months back. On investigation, Hb is 4.5 gms, total count is 60,000, and platelet count is 2 lakhs. Immunophenotyping shows CD10+, CD19+, CD117+, MPO+, and CD33-. What is the most probable diagnosis?
An 80-year-old asymptomatic woman on routine examination was detected to have a monoclonal spike on serum electrophoresis (IgG levels 1.5 g/dl). Bone marrow revealed 8% plasma cells. Which of the following represents the most likely diagnosis?
Explanation: Explanation: Target cells (also known as **Codocytes**) are erythrocytes with a central spot of hemoglobin surrounded by a clear ring and a peripheral rim of hemoglobin, resembling a "bull’s eye." The fundamental mechanism behind target cell formation is an **increase in the surface area-to-volume ratio** of the red blood cell [1]. * **Liver Disease (Option A):** In obstructive jaundice or chronic liver disease, there is an increase in cholesterol and phospholipids in the RBC membrane. This increases the surface area of the membrane relative to the cell volume, leading to "floppy" cells that collapse into a target shape. * **Post-Splenectomy (Option B):** The spleen normally removes excess membrane from young RBCs. In its absence (or in functional asplenia), the excess membrane remains, resulting in a higher surface area-to-volume ratio [2]. * **Thalassemia (Option C):** In hemoglobinopathies like Thalassemia (and HbC disease), there is a **decrease in intracellular hemoglobin volume** (hypochromia). Since the volume inside the cell decreases while the membrane surface area remains relatively constant, the cell collapses into a target shape [1]. **High-Yield Clinical Pearls for NEET-PG:** * **Mnemonic (HALT):** **H**bC disease, **A**splenia, **L**iver disease, **T**halassemia. * **Artifact:** Target cells can sometimes be an artifact of slow drying in humid environments. * **Differential Diagnosis:** While target cells are classic for Thalassemia, they are **not pathognomonic**; always correlate with the Mentzer Index (MCV/RBC count <13 suggests Thalassemia). * **Post-Splenectomy Findings:** Along with target cells, look for **Howell-Jolly bodies**, Pappenheimer bodies, and Heinz bodies on the peripheral smear [2]. **References:** [1] Kumar V, Abbas AK, et al.. Robbins and Cotran Pathologic Basis of Disease. 9th ed. Red Blood Cell and Bleeding Disorders, pp. 640-641, 648. [2] Kumar V, Abbas AK, et al.. Robbins and Cotran Pathologic Basis of Disease. 9th ed. Red Blood Cell and Bleeding Disorders, pp. 644-645.
Explanation: **Explanation:** The clinical presentation of a 63-year-old woman with **Bence Jones proteinuria**, chronic renal failure, and **punched-out lytic bone lesions** (rounded areas of decreased density) is classic for **Multiple Myeloma** [3]. **Why Amyloidosis is Correct:** In Multiple Myeloma, neoplastic plasma cells produce excessive amounts of monoclonal immunoglobulin light chains (Bence Jones proteins) [1]. These light chains are filtered by the glomerulus and can be deposited in various tissues, including the kidney, as **AL (Amyloid Light-chain) Amyloidosis** [4]. This deposition leads to nephrotic syndrome and progressive renal failure. On biopsy, this appears as extracellular eosinophilic amorphous material that shows **apple-green birefringence** under polarized light with Congo red stain. **Analysis of Incorrect Options:** * **A. Pneumocystis carinii pneumonia:** While myeloma patients are immunocompromised due to hypogammaglobulinemia, this is a pulmonary complication, not a finding on a **renal biopsy**. * **B. Sclerodactyly:** This is a feature of Systemic Sclerosis (Scleroderma), characterized by skin thickening of the fingers, and is unrelated to plasma cell dyscrasias. * **C. Chronic myelogenous leukemia (CML):** CML is a myeloproliferative neoplasm involving the $t(9;22)$ translocation. It does not cause lytic bone lesions or Bence Jones proteinuria. **High-Yield Clinical Pearls for NEET-PG:** * **CRAB Criteria for Myeloma:** **C**alcium (high), **R**enal insufficiency, **A**nemia, **B**one lesions [2]. * **Myeloma Kidney:** The most common renal cause of death is "Cast Nephropathy," where Bence Jones proteins form large, waxy, eosinophilic intratubular casts [1]. * **Diagnosis:** Serum/Urine Protein Electrophoresis (M-spike) and Bone marrow biopsy (>10% clonal plasma cells). * **Amyloid Staining:** Congo red is the gold standard; AL amyloid is the specific type associated with plasma cell dyscrasias [4]. **References:** [1] Kumar V, Abbas AK, et al.. Robbins and Cotran Pathologic Basis of Disease. 9th ed. The Kidney, pp. 942-943. [2] Cross SS. Underwood's Pathology: A Clinical Approach. 6th ed. Common Clinical Problems From Blood And Bone Marrow Disease, pp. 618-619. [3] Cross SS. Underwood's Pathology: A Clinical Approach. 6th ed. Common Clinical Problems From Blood And Bone Marrow Disease, pp. 616-617. [4] Kumar V, Abbas AK, et al.. Robbins and Cotran Pathologic Basis of Disease. 9th ed. Diseases of the Immune System, pp. 266-267.
Explanation: **Explanation:** Sickle cell anemia (HbS) is an autosomal recessive hemoglobinopathy characterized by a **point mutation** in the **beta ($\beta$)-globin gene** located on chromosome 11. [1] **Why Option B is correct:** The defect involves a single nucleotide substitution (missense mutation) where **Adenine is replaced by Thymine (GAG $\rightarrow$ GTG)**. This results in the substitution of the amino acid **Valine for Glutamic acid** at the **6th position** of the $\beta$-globin chain [1]. This change creates a hydrophobic pocket that causes hemoglobin to polymerize under deoxygenated conditions, leading to the characteristic "sickle" shape of red blood cells [1]. **Why other options are incorrect:** * **Option A:** Defects in the alpha ($\alpha$)-globin chain (located on chromosome 16) are associated with **$\alpha$-Thalassemia**, not sickle cell disease [1]. * **Option C & D:** Sickle cell disease is specifically a $\beta$-chain disorder. While hemoglobin is a tetramer ($\alpha_2\beta_2$), the primary genetic lesion is restricted to the $\beta$-locus [1]. **High-Yield NEET-PG Pearls:** * **Inheritance:** Autosomal Recessive [1]. * **Metabisulfite Test:** Used for screening (induces sickling). * **Electrophoresis:** HbS moves **slowest** towards the anode compared to HbA and HbF (due to loss of negative charge from Glutamic acid). * **Protective Effect:** Heterozygotes (Sickle cell trait) have a selective advantage against *Plasmodium falciparum* malaria. * **Complications:** Vaso-occlusive crises, Autosplenectomy (Howell-Jolly bodies), and Salmonellosis (Osteomyelitis) [1]. **References:** [1] Cross SS. Underwood's Pathology: A Clinical Approach. 6th ed. Common Clinical Problems From Blood And Bone Marrow Disease, pp. 598-601.
Explanation: ### Explanation The correct diagnosis is **Plasmacytoma** (specifically, Solitary Plasmacytoma of Bone) [1]. #### Why Plasmacytoma is Correct? A Solitary Plasmacytoma is a localized neoplastic proliferation of monoclonal plasma cells. The diagnostic criteria are met here because: 1. **Localized Lesion:** There is a single lytic bone lesion confirmed by histology. 2. **Low Marrow Involvement:** Bone marrow biopsy shows **<10% plasma cells**, indicating the disease is not systemic [1]. 3. **Minimal Systemic Markers:** A small M-protein (M-spike) may be present, but there is no evidence of CRAB features (Calcium elevation, Renal failure, Anemia, or multiple Bone lesions) other than the single primary lesion [1]. #### Why Other Options are Incorrect? * **Multiple Myeloma (MM):** Requires **≥10% clonal plasma cells** in the bone marrow OR biopsy-proven plasmacytoma **PLUS** one or more CRAB features (multiple lytic lesions, anemia, hypercalcemia, or renal insufficiency) [2, 3]. This patient has <10% marrow involvement and only one lesion. * **Smoldering Myeloma:** Characterized by an M-protein ≥3 g/dL or marrow plasma cells between 10–60% [1], but crucially, there are **no end-organ damage (CRAB)** or lytic lesions. The presence of a lytic lesion excludes this diagnosis. * **Lymphoma:** While some lymphomas (like DLBCL) can cause lytic lesions, the histology specifically revealed **monoclonal plasma cells**, which is pathognomonic for plasma cell dyscrasias. #### NEET-PG High-Yield Pearls * **Solitary Plasmacytoma:** Most common sites are the axial skeleton (vertebrae). About 50% of cases eventually progress to Multiple Myeloma. * **Diagnostic Cut-off:** Remember the **10% rule**. <10% marrow plasma cells + single lesion = Plasmacytoma; >10% marrow plasma cells + CRAB = Multiple Myeloma. * **Imaging:** For NEET-PG, remember that **MRI** is more sensitive than a skeletal survey for detecting early marrow involvement in plasmacytomas. **References:** [1] Kumar V, Abbas AK, et al.. Robbins and Cotran Pathologic Basis of Disease. 9th ed. Diseases of White Blood Cells, Lymph Nodes, Spleen, and Thymus, pp. 606-608. [2] Cross SS. Underwood's Pathology: A Clinical Approach. 6th ed. Common Clinical Problems From Blood And Bone Marrow Disease, pp. 617-618. [3] Cross SS. Underwood's Pathology: A Clinical Approach. 6th ed. Common Clinical Problems From Blood And Bone Marrow Disease, pp. 616-617.
Explanation: **Explanation:** The correct answer is **A. 20-24°C for 5 days.** **Underlying Medical Concept:** Platelets are unique among blood components because they must be stored at **room temperature (20-24°C)** with **continuous agitation**. Agitation (via a platelet agitator) is crucial to prevent platelet aggregation and to facilitate gas exchange, maintaining a pH above 6.0. If platelets are refrigerated (4-8°C), they undergo "cold-induced activation" and structural changes (becoming spherical), leading to rapid clearance by the recipient's spleen after transfusion. The 5-day limit is strictly enforced primarily due to the **risk of bacterial proliferation**, which is higher at room temperature compared to refrigerated components. **Analysis of Incorrect Options:** * **B & D (8 days):** Extending storage to 8 days significantly increases the risk of life-threatening bacterial sepsis. While some newer technologies (like pathogen reduction or large-volume delayed sampling) can extend shelf life to 7 days, the standard board-exam answer remains 5 days. * **C & D (4-8°C):** This is the storage temperature for **Whole Blood and Packed Red Blood Cells (PRBCs)**. Refrigeration preserves red cell metabolic activity but renders platelets non-functional for transfusion purposes. **High-Yield Clinical Pearls for NEET-PG:** * **Agitation:** Essential to prevent lactic acidosis and maintain platelet viability. * **Bacterial Sepsis:** Platelets are the blood component most commonly associated with transfusion-transmitted bacterial infections (most common: *Staphylococcus epidermidis*). * **Dose:** One unit of Random Donor Platelets (RDP) typically increases the count by 5,000–10,000/µL, whereas one unit of Single Donor Platelets (SDP) increases it by 30,000–60,000/µL. * **Fresh Frozen Plasma (FFP):** Stored at **-18°C or colder** for up to 1 year.
Explanation: **Explanation:** The correct answer is **1.5 gm/dL**. **1. Why 1.5 gm/dL is correct:** Cyanosis is a clinical sign characterized by the bluish discoloration of the skin and mucous membranes. It occurs when a specific absolute amount of "dark" (deoxygenated or abnormal) hemoglobin is present in the blood. In the case of **Methemoglobinemia**, iron is in the ferric ($Fe^{3+}$) state rather than the ferrous ($Fe^{2+}$) state, rendering it unable to bind oxygen. Because methemoglobin has a much darker, brownish-blue pigment than deoxyhemoglobin, it produces visible cyanosis at a much lower concentration—specifically **1.5 gm/dL**. **2. Analysis of Incorrect Options:** * **5 gm/dL (Option A):** This is the threshold for **central cyanosis** caused by **reduced (deoxy) hemoglobin**. In patients with normal hemoglobin levels, cyanosis becomes visible when the absolute concentration of deoxygenated hemoglobin exceeds 5 gm/dL. * **2 gm/dL (Option B):** This is an incorrect distractor; it does not correspond to a standard clinical threshold for cyanosis. * **12 gm/dL (Option D):** This value is near the normal range for total hemoglobin. If methemoglobin reached this level, it would be life-threatening (causing severe hypoxia, seizures, or coma). **3. High-Yield Clinical Pearls for NEET-PG:** * **Clinical Presentation:** Patients often present with "Chocolate-colored blood" and cyanosis that does not improve with supplemental oxygen. Free hemoglobin can oxidize to methemoglobin, which is brown in color [1]. * **The "Saturation Gap":** A classic finding where there is a discrepancy between the $SaO_2$ measured by pulse oximetry (which is falsely low/fixed) and the $PaO_2$ on ABG (which remains normal). * **Treatment:** The drug of choice is **Methylene Blue**, which acts as a cofactor for NADPH-methemoglobin reductase to reduce $Fe^{3+}$ back to $Fe^{2+}$. * **Common Triggers:** Nitrites, Benzocaine, Dapsone, and Sulfonamides. **References:** [1] Kumar V, Abbas AK, et al.. Robbins and Cotran Pathologic Basis of Disease. 9th ed. Red Blood Cell and Bleeding Disorders, pp. 639-640.
Explanation: ***Annexin A1*** - **Annexin A1** is the specific immunohistochemical marker for **hairy cell leukemia (HCL)**, which presents with massive splenomegaly and characteristic "hairy cells" on peripheral smear. - It helps distinguish **classic HCL** from **HCL-variant** and other B-cell lymphomas, making it the diagnostic marker of choice. *CD23* - **CD23** is primarily used as a marker for **chronic lymphocytic leukemia (CLL)** and **small lymphocytic lymphoma**. - CLL typically presents with **lymphadenopathy** rather than massive splenomegaly, and lacks the characteristic hairy cell morphology. *CD21* - **CD21** is a marker for **B-cells** and **follicular dendritic cells**, but is not specific for any particular lymphoid malignancy. - It does not help differentiate **hairy cell leukemia** from other B-cell disorders and lacks diagnostic specificity. *Cyclin D1* - **Cyclin D1** is the characteristic marker for **mantle cell lymphoma**, which has a different clinical presentation and morphology. - Mantle cell lymphoma typically affects **elderly males** with lymphadenopathy and **gastrointestinal involvement**, not isolated massive splenomegaly.
Explanation: **Paroxysmal Nocturnal Hemoglobinuria (PNH)** is an acquired clonal hematopoietic stem cell disorder [2]. The fundamental defect is a mutation in the **PIGA (Phosphatidylinositol Glycan Class A)** gene [2]. This gene is essential for the synthesis of **GPI (Glycosylphosphatidylinositol) anchors**, which are glycolipids that attach various proteins to the cell membrane. In PNH, the absence of GPI anchors leads to a deficiency of membrane-bound complement regulatory proteins, most notably **CD55 (Decay Accelerating Factor)** and **CD59 (Membrane Inhibitor of Reactive Lysis)** [1]. Without these "shields," red blood cells become hypersensitive to complement-mediated lysis, leading to intravascular hemolysis [1]. **Analysis of Incorrect Options:** * **A, B, and C (Ankyrin, Band 3, and Spectrin):** These are structural proteins of the RBC membrane cytoskeleton [3]. Defects in these proteins (most commonly Ankyrin) lead to **Hereditary Spherocytosis**, not PNH [3]. These defects result in vertical instability of the membrane, leading to the formation of spherocytes and extravascular hemolysis in the spleen [3]. **High-Yield Clinical Pearls for NEET-PG:** * **Triad of PNH:** Hemolytic anemia, Pancytopenia, and Venous thrombosis (often in unusual sites like the Budd-Chiari syndrome) [1]. * **Gold Standard Diagnosis:** Flow cytometry to demonstrate the absence of CD55 and CD59 on RBCs and leukocytes. * **Ham’s Test & Sucrose Lysis Test:** Older screening tests (now largely replaced by flow cytometry). * **Treatment:** Eculizumab (a monoclonal antibody against complement protein C5). * **Complication:** Increased risk of transformation into Acute Myeloid Leukemia (AML) or Aplastic Anemia. **References:** [1] Kumar V, Abbas AK, et al.. Robbins and Cotran Pathologic Basis of Disease. 9th ed. Red Blood Cell and Bleeding Disorders, pp. 650-651. [2] Cross SS. Underwood's Pathology: A Clinical Approach. 6th ed. Common Clinical Problems From Blood And Bone Marrow Disease, pp. 601-602. [3] Kumar V, Abbas AK, et al.. Robbins and Cotran Pathologic Basis of Disease. 9th ed. Red Blood Cell and Bleeding Disorders, pp. 640-641.
Explanation: **Explanation:** The diagnosis of **Mixed Phenotypic Acute Leukemia (MPAL)** is based on the presence of markers from two different lineages on the same blast population (biphenotypic) or two distinct populations of blasts (bilineal). In this case, the immunophenotype shows a combination of: * **B-cell lineage markers:** CD10 and CD19 [1]. * **Myeloid lineage markers:** MPO (the most specific marker for myeloid differentiation) and CD117. According to the WHO classification, the expression of **MPO** (via flow cytometry or immunohistochemistry) is sufficient to assign a myeloid lineage, while **CD19** (strong) along with other B-markers like **CD10** confirms B-lineage involvement. Since both criteria are met, it is classified as MPAL. **Analysis of Incorrect Options:** * **A. Acute Lymphoblastic Leukemia (ALL):** While CD10 and CD19 are classic B-ALL markers, the presence of MPO and CD117 rules out a pure lymphoid diagnosis [1]. * **B. Acute Myeloid Leukemia (AML):** Although MPO and CD117 are myeloid markers, the strong expression of B-cell markers (CD10, CD19) precludes a diagnosis of pure AML. * **C. Undifferentiated Leukemia:** This diagnosis is reserved for cases where blasts lack any lineage-specific markers (negative for MPO, T-cell, and B-cell markers). **Clinical Pearls for NEET-PG:** * **MPO** is the "gold standard" for myeloid lineage. * For **B-lineage** assignment in MPAL: Strong CD19 + one other B-marker (CD10, CD22, or CD79a) is required. * For **T-lineage** assignment: Cytoplasmic CD3 is the most specific marker. * MPAL generally carries a **poorer prognosis** compared to lineage-specific acute leukemias and often requires more intensive, hybrid chemotherapy protocols. **References:** [1] Kumar V, Abbas AK, et al.. Robbins and Cotran Pathologic Basis of Disease. 9th ed. Diseases of White Blood Cells, Lymph Nodes, Spleen, and Thymus, pp. 599-600.
Explanation: ### Explanation The correct diagnosis is **Monoclonal Gammopathy of Unknown Significance (MGUS)**. This diagnosis is based on the classic triad of findings presented in the case: 1. **Serum M-protein < 3 g/dL** (Patient has 1.5 g/dL) [1]. 2. **Bone marrow plasma cells < 10%** (Patient has 8%) [4]. 3. **Absence of end-organ damage** (Patient is asymptomatic; no CRAB features: Calcium elevation, Renal insufficiency, Anemia, or Bone lesions) [5]. #### Why other options are incorrect: * **Multiple Myeloma:** Requires bone marrow plasma cells **≥ 10%** (or biopsy-proven plasmacytoma) PLUS evidence of end-organ damage (**CRAB features**) or specific biomarkers of malignancy (e.g., involved:uninvolved light chain ratio ≥ 100) [1]. * **Indolent (Smoldering) Myeloma:** Characterized by an M-protein **≥ 3 g/dL** or bone marrow plasma cells between **10–60%**, but like MGUS, it lacks end-organ damage (CRAB features) [3]. * **Waldenstrom’s Macroglobulinemia:** This is a lymphoplasmacytic lymphoma characterized by a monoclonal **IgM** spike (not IgG) and hyperviscosity symptoms [2]. #### NEET-PG High-Yield Pearls: * **MGUS** is the most common plasma cell dyscrasia in the elderly (found in ~3% of the population >50 years). * **Progression:** MGUS carries a **1% annual risk** of progression to Multiple Myeloma. * **M-protein type:** In MGUS, the spike is most commonly **IgG**, whereas in Waldenstrom’s, it is always **IgM** [2]. * **Management:** For MGUS, the standard of care is "watchful waiting" (observation) rather than chemotherapy. **References:** [1] Kumar V, Abbas AK, et al.. Robbins and Cotran Pathologic Basis of Disease. 9th ed. Diseases of White Blood Cells, Lymph Nodes, Spleen, and Thymus, pp. 608-609. [2] Cross SS. Underwood's Pathology: A Clinical Approach. 6th ed. Common Clinical Problems From Blood And Bone Marrow Disease, pp. 616-617. [3] Kumar V, Abbas AK, et al.. Robbins and Cotran Pathologic Basis of Disease. 9th ed. Diseases of White Blood Cells, Lymph Nodes, Spleen, and Thymus, pp. 606-607. [4] Cross SS. Underwood's Pathology: A Clinical Approach. 6th ed. Common Clinical Problems From Blood And Bone Marrow Disease, pp. 617-618. [5] Kumar V, Abbas AK, et al.. Robbins and Cotran Pathologic Basis of Disease. 9th ed. Diseases of White Blood Cells, Lymph Nodes, Spleen, and Thymus, p. 608.
Anemias: Classification and Approach
Practice Questions
Hemolytic Anemias
Practice Questions
Myeloproliferative Neoplasms
Practice Questions
Myelodysplastic Syndromes
Practice Questions
Acute Leukemias
Practice Questions
Chronic Leukemias
Practice Questions
Lymphomas and Lymphoid Neoplasms
Practice Questions
Plasma Cell Disorders
Practice Questions
Bleeding Disorders
Practice Questions
Thrombotic Disorders
Practice Questions
Get full access to all questions, explanations, and performance tracking.
Start For Free